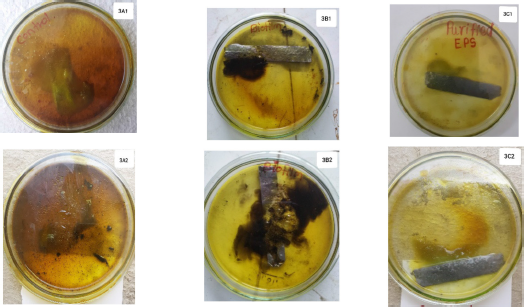

1. INTRODUCTION
Corrosion is nothing but the disintegration of metal due to the physicochemical interaction between metals and the environment [1]. Corrosions can be caused because of some environmental factors such as high temperature, high salt, acidic condition, and high humidity [2]. Mitigation of corrosion is the biggest challenge for many industries; many of them have spent lot of money to overcome this problem. Verma et al. [3] reported that the maintenance cost of corrosion-related issues for a particular country varies from 1% to 5% of its gross national product. Nevertheless, disasters such as casualties, economic losses, and environmental side effects are triggered by corrosion, which happen quite frequently [4]. Corrosion can be controlled by selecting appropriate structural material for specific use or by creating a barrier between the metal and medium to reduce the physicochemical interaction [5]. The method used to control the corrosion usually makes use of unsafe and uneconomic product such as volatile organic compounds, which are responsible for causing major human health disorders. This induced the search for green corrosion inhibitors [6]. A new approach to mitigate corrosion is the use of exopolysaccharides (EPS), which forms the anti-corrosive layer at the metal interface .
EPSs are made up of a chain of monosaccharides, a small amount of phospholipid, and proteins which are responsible for decreasing the electrostatic repulsion between cell and surface, which eventually leads to biofilm formation. The physicochemical properties of EPS depend on the biological source and composition of media [7].
Pullulan is an EPS that consists of a series of maltotriose in which α-1,4 glycosidic bonds are responsible for linking glucose units, whereas α-1,6 glycosidic bonds are attributed to the branching in pullulan [8]. The systematized (1→4) and (1→6) glycosidic linkages contribute to certain properties of pullulan like high elasticity and soluble property [9]. Pullulan shows insolubility in organic solvents and solubility in water. After solubilization in water, it results in the formation of a translucent and sticky solution [10].
Pullulan is normally synthesized by Aureobasidium pullulans [11]. Aureobasidium pullulans belongs to Ascomycetes and order Dothideales. It has a wide industrial application. Since pullulan contains a large number of nucleophilic oxygen atoms, it plays an important role in inhibiting corrosion in an acidic medium.
Pullulan from A. pullulans can serve as a better, and may be novel, source to overcome the problem of corrosion. Therefore, the present study aims to isolate potent pullulan producing A. pullulans from leaves of vegetables, to extract the pullulan, and to evaluate the potential of biofilm of A. pullulans, and to mitigate the corrosion of mild steel.
2. MATERIALS AND METHODS
2.1. Isolation of A. pullulans
A total 150 leaf samples of spinach (Spinacia olevacea), cauliflower (Brassica oleracea), and coriander (Coriandrum sativum) were collected in presterilized polythene bags to prevent the interference of contaminants.
Isolation of A. pullulans strains from spinach, cauliflower, and coriander leaves were carried out by using Pollock and Thone’s [12] method. One half gram of washed and cut leaves were immersed in 10 ml of sterile distilled water and kept in shaking condition at 120 rpm for 3 days at 28?. 50 ml of the enrichment medium [(g/l): 2.0 g of yeast extract, 0.5 g of (NH4)2HPO4, 1.0 g of NaCl, 0.2 g of MgSO4.7H2O, 3.0 g of K2HPO4, 0.01 g each of FeSO4, MnSO4, and ZnSO4, pH 7, 20.0 g sucrose, and 10 mg ml−1 chloramphenicol] was inoculated in 0.5 ml of water soaked leaves sample solution. After 2 days of incubation in a rotary shaker, the culture was kept stationary in order to be free from filaments and clumps.
About 100 μl of the diluted liquid culture was spread on the agar medium of same composition.
After incubation at 25? for 3 days, the isolated colonies were studied for cultural, morphological, biochemical, and molecular characterization.
2.2. Characterization of Natural Isolates of A. pullulans
The yeast-like fungus was identified in accordance with morphological observation and nutritional physiology tests. After microscopic study, biochemical characterization of selected isolates was carried out with reference to its potential to use various carbon and nitrogen sources by using yeast nitrogen base agar and yeast carbon base agar, containing 1% carbon and 1% nitrogen, respectively. The selected isolate was tested for its capacity to produce different enzymes, such as amylase, cellulase, xylanase, gelatinase, protease, and urease by using yeast nitrogen base agar, containing 1% of appropriate substrate (1% w/v), followed by the addition of the corresponding reagent. Amylase was detected by using iodine solution. Congo red (0.5%) was used for detection of the clear zone because of hydrolysis of xylan. Gelatinase production was detected by the formation of clear area around the colony after addition of 15% HgCl2 in 20% HCl. Protease enzyme was detected by using 10% HCl, which leads to the formation of a clear zone around the colony. Urease production was detected by using the phenol red indicator, followed by the development of red color. Identification of selected isolate was confirmed by DNA sequencing of internal ttranscribed spacer )region. The Basic Local Alignment Search Tool was used for alignment and comparison of the DNA sequence of selected strain with database of sequences in the National Center for Biotechnology Information. The outcomes were given in the form of percentage homology between the sequence of selected strain and the related sequences from the database.
2.3. EPS Production
Aureobasidium pullulans spi 10 was inoculated in Sabouraud dextrose medium and incubated in shaking condition (120 rpm) for 48 hours at 25?. One percent of inoculum containing 107 cells/ml was used for EPS production. A production medium containing 2 g of dextrose, 0.06 g of ammonium sulfate (NH4)2SO4, 0.5 g of dipotassium hydrogen orthophosphate (K2HPO4), 0.1 g of sodium chloride (NaCl), 0.04 g of yeast extract in 100 ml of autoclaved distilled water, and pH 5 was used for the production of EPS. 215 × 105 cells per ml were inoculated in 100 ml production medium in each flask. All three flasks were incubated at 28? in rotary shaker incubator at 200 rpm for the time intervals of 48, 72, and 96 hours [13].
2.4. Pullulan Precipitation and Dry Weight Estimation
Aureobasidium pullulans spi 10 culture was centrifuged at 10,000 × g for 10 minutes to separate the biomass from the supernatant. The dry weight of biomass was estimated by drying the sediment at 100 for 24 hours. Pullulan was precipitated by adding double volume of ice-chilled isopropyl alcohol to cell-free supernatant. This mixture was incubated for 24 hours at 5°C for precipitation of EPS, followed by centrifugation at 2,500× g for 20 minutes at 4°C [13]. After removal of supernatant, the precipitates were dissolved in deionized water. It was again precipitated with isopropyl alcohol. The obtained precipitate was washed with acetone and deionized water. The precipitate was dried at 80?.
2.5. Determination of Pullulan
The precipitated pullulan (EPS) was taken in an evaporating dish, and the weight of the empty dish was noted before the addition of precipitated pullulan. After complete drying, the evaporating dish was cooled and again the weight of evaporating dish with pullulan was taken on a digital weighing balance. The EPS was expressed as amount of pullulan in terms of gram produced per 100 ml of fermented broth. The EPS in % was determined by subtracting weight of empty evaporating dish from the weight of evaporating dish with EPS in grams.
2.6. Characterization of EPS
The Folin–Lowry method and phenol sulfuric acid method were used to estimate the protein and carbohydrate of EPS, respectively [14,15]. Characterization of EPS was carried out by Fourier transform infrared spectroscopy (FTIR) [16]. illirams2 mg of EPS was mixed with 200 mg of KBr and compact disks of 3 mm diameter were prepared. The disks were scanned in the range of 4,000–500 cm−1 with a resolution 4 cm−1 and using 32 scans.
2.7. Potential of Pullulan and Biofilm of A. pullulans spi 10 to Mitigate the Corrosion of Steel Coupons
The study of the corrosive stability of steel samples was carried out by using the Gravimetric method [17].
2.7.1. Coupon preparation
A carbon steel plate with dimensions of 7 × 2 cm and having the percentage weight composition of 0.0100 Si, 1.036 Mn, 0.0343 Cr, 0.0076 Mo, 0.0424 Ni, 0.0045 S, 0.0101 P, 0.05172 Ti, 0.0811 C, 0.0082 Co, 0.0425 Al, 0.0276 Cu, and rest of Fe were prepared for studying corrosive properties.
Coupons were rubbed with polished paper on both sides and then rinsed with distilled water thrice. Grease was removed with the help of acetone. Metal coupons were sterilized by immersing into ethanol solution and flaming on burner before exposure to any treatment.
2.7.2. Formation of biofilm of A. pullulans spi 10 on metal coupons
Approximately 10 ml of the 48-hour-old A. pullulans spi 10 culture was taken in the sterile petri plate. The sterilized metal coupons were immersed in it so as to form a biofilm within 3–5 days.
2.7.3. Formation of pullulan layer on metal coupons
Pullulan powder was dissolved in water to make the final concentration of 5 mg/ml. Sterile metal coupons were layered with EPSs (pullulan) by dipping repeatedly in purified pullulan solution and dried with dryer.
2.7.4. Immersion of metal coupons in HCl
Sterilized metal coupons without protective agents (control), metal coupons with biofilm of A. pullulans spi 10, and metal coupons coated with pullulans were immersed in 5 ml of 70% concentrated HCl for 48 hours. After every 24 hours, the metal coupons were observed carefully, dried, and then weighed on digital weighing balance.
2.8. Parameters of Corrosion
After exposure of metal coupon to concentrated HCl, metal coupons were rinsed with water, dehydrated in an oven, and reweighed on digital weighing balance so as to find out the weight reduction. The parameters of corrosion such as the rate of corrosion, the degree of protection, and the coefficient of protection were studied [18].
2.8.1. Corrosion rate (K)
The corrosion rate K (g/cm2·hour) was calculated as follows:
? (g/cm2·hour) = ΔG / S τ (1)
where ? is the corrosion rate;
ΔG is reduction of mass because of corrosion, g;
S is the area of coupon, cm2;
Τ is time period of the corrosion, hour.
2.8.2. Degree of protection (Z)
The inhibitory properties of biofilm and EPS (pullulan) were also studied by calculating the degree of protection (Z) and coefficient of protection (γ). The degree of protection (Z) of metal coupon was calculated as follows:
Z = (K0 – Ki) / K0 × 100, % (2)
where K0 is the corrosion rate in control media;
Ki is the corrosion rate in test media.
2.8.3. Coefficient of protection (γ)
(γ) = K0 / Ki
where K0 is the corrosion rate in control media;
Ki is the corrosion rate in test media
2.9. Characterization of Metal Coupons
Surface morphology of steel coupons was studied by using scanning electron microscopy (SEM).
SEM analysis was followed by FTIR analysis to explore the specific functional group of pullulan which is attributed to the formation of linkage with the metal surface [16,19].
3. RESULTS AND DISCUSSION
3.1. Isolation and Screening of Pullulan Producing A. pullulans
A total of 30 isolates of A. pullulans were isolated from leaves of B. oleracea, C. sativum, and S. olevacea. All these isolates were screened for pullulan production. Out of which A. pullulan spi 10 isolated from S. olevacea showed maximum pullulan production (data not shown); therefore, the same strain was used for further study.
3.2. Characterization and Identification of A. pullulans spi 10
Microscopic characterization of A. pullulans spi 10 exhibited the polymorphism as it could grow as a single cell yeast or as a mycelia based on environmental conditions. Colonies were initially smooth, but later on got covered with slime; after 24 hours of incubation the colonies were whitish, faint pink, or brown in color; and the colonies became dark due to melanin production by chlamydospore.
Biochemical characterization of A. pullulans spi 10 strain with reference to its potential to utilize different carbon and nitrogen sources and its capacity to synthesize various enzymes is presented in Table 1. Aureobasidium pullulans spi 10 was unable to assimilate methanol, these findings are in line with the data given by Takahashi et al. [20] who has mentioned that A. pullulans strain 14 was unable to grow on methanol. The selected isolate could utilize glucose, fructose, sucrose, maltose, lactose, and mannitol. Aureobasidium pullulans spi 10 could grow on different carbon sources, on the basis of its ability to form a zone of clearance. After the addition of iodine, amylase production was confirmed. The ability of the culture to grow on a sucrose-containing medium revealed the production of invertase, whereas the growth of A. pullulans spi 10 on a lactose-containing medium showed the potential of β galactosidase production. Gaur et al. [21] reported that A. pullulans has the ability to produce a variety of enzymes having a wide industrial application.
![]() | Table 1: Carbon and nitrogen assimilation by A. pullulans spi 10. [Click here to view] |
As far as nitrogen sources are concerned A. pullulans spi 10 could use ammonium nitrates, sodium nitrates, sodium nitrite, asparagine, and peptone as the nitrogen source for its growth, when each of this nitrogen source was included as sole nitrogen source in the medium. Aureobasidium pullulans spi 10 could tolerate NaCl up to 10% and temperature up to 40?. Aureobasidium pullulans spi 10 could grow on a medium having pH values from 3.0 to 11.0.
Further identification of the selected strain at molecular level was carried out by 18S rDNA sequence methodology. The phylogenetic relationship between A. pullulans isolates (♦) spinach and indicative members is shown in Figure 1. Aureobasidium pullulans spi 10 (JN807329) was submitted to Gene bank. The neighbor-joining method was used for building of phylogenetic tree.
It can be seen from Figure 2 that A. pullulans spi 10 after 5 days of incubation showed maximum pullulan yield (4.53 ± 0.34 g/100 ml); further incubation resulted in a decrease in pullulan yield. Young culture usually produces large pullulan as compare to old culture; this may be because of thickening of cell wall, presence of chlamydospore, and melanin production [22]. Catley [23] has reported that pullulan is produced when cells are in the long-delayed log phase and stationary phase of growth. Wu et al. [24], reported maximum pullulan yield (2.943 g/100 ml) by A. pullulans AP329, which is less than pullulan produced by A. pullulans spi 10. Youssef et al. [25] revealed the 3.10 g/100 ml pullulan production by A. pullulans p56 in synthetic medium.
Nitrogen source, mainly ammonium ion (NH4+), affects the pullulan production. Abatement of nitrogen from media is the cause of EPS synthesis by A. pullulans [26–28].
3.3. Chemical Analysis of EPS
The dried EPS was used for estimation of total carbohydrate, reducing sugar and protein content. The carbohydrate content determined by the phenol sulfuric acid method was 4.2 ± 0.06 g/100 ml and the total protein content was 0.2 ± 0.003 mg/100 ml measured by the Folin–Lowry method. The protein content of the EPS was found to be very low as compared to total carbohydrate content. Even though it is present in low proportion, they are responsible for the anionic properties of the EPS and it also plays an important role as electron donor or acceptor in redox reaction in biofilm [29]. Some studies have shown that the protein of EPS can control the binding of microbial cells to various hard facet. Karunakaran and Biggs [30] reported that electrostatic attractions between charged proteins of EPS are responsible for the stability of biofilm matrix.
3.4. Potential of Pullulan and Biofilm to Mitigate the Corrosion
Potential of pullulan and biofilm to mitigate the corrosion were studied by calculating the rate of corrosion, the degree of protection, and the coefficient of protection with respect to different metal coupons: metal coupons with biofilm of A. pullulans spi 10 and metal coupons with layer of pullulan. Metal coupon without any protective agent was considered as a control.
Analysis of variance (ANOVA) test was carried out for control, biofilm, and pullulan treatment, where null hypothesis (Ho) is considered as: all three treatments resulted into equal weight of metal coupons after 24 hours of treatment, where p = 2 × 10−23. This p value is very less than 0.05. In this situation, we reject the null hypothesis. It means that average weight of three treatments is significantly different.
In the next step, we performed t-test by considering two factors at a time. This was performed by considering weight of coupons after 24 hours exposure to HCl. Table 3 depicts that average weight of control is less than average weight of steel coupons coated with biofilm and pullulan. It also shows that average weight of steel coupons coated with biofilm is less than average weight of steel coupons coated with pullulan. This t-test strongly supports the statement that protective agent either the biofilm of A. pullulans spi 10 or pullulan both contribute significantly to mitigating the corrosion of steel coupons. T-test also endorsed that pullulan coating is better when compared to coating by biofilm of A. pullulans spi 10. Similarly, we performed ANOVA and t-test for data which was collected after exposing the steel coupons to HCl up to 48 hours. We found the same result supporting the statement that pullulan treatment is better than biofilm treatment.
Table 4 shows that corrosion rate of steel coupons without any protective agent is 2.67 × 10−3 g/cm2·hour, whereas with biofilm of A. pullulans spi 10 it is 2.023 × 10−3 g/cm2·hour. The corrosion rate of steel coupons with biofilm is less than that of control, the coefficient of protection shown by the biofilm is 1.32 with almost 25% of degree of protection.
![]() | Table 2: Potential of pullulan and biofilm to mitigate the corrosion of metal coupon after treatment of concentrated HCl. Steel coupons with biofilm of A. pullulans spi 10, with pullulan, and steel coupons without any protective agents were immersed in concentrated HCl up to 48 hours, after every 24 hours steel coupons were washed and dried in an oven and reweighed on digital weighing balance to estimate the weight loss. [Click here to view] |
Corrosion rate of steel coupons with layer of pullulan was comparatively very low, it was almost seven times less than that of control, and it was found to be 0.348 × 10−3 g/cm2·hour. The degree of protection shown by coating of pullulan is almost 86% with a coefficient of protection = 7.7. This could be because of formation of metal pullulan complex which form the protective layer on the exterior of metal. Similar type of work was carried out by Ignatova-Ivanova and Ivanov [6] on Lactobacillus delbrueckii B5c where scientists used the cell-free supernatant of Lactobacillus culture and reported 72% of the degree of protection with 3.70 coefficient of protection of corrosion of steel coupons. Ignatova-Ivanova and Ivanov [6] worked on the application of biofilm of Delta marina, having ability to produce EPS, to control the corrosion of mild steel. Charitha and Padmalatha [31] reported the 81% inhibition efficiency of dextran to inhibit the corrosion of 6061 Al-15% (v) SiC(P) composite material (Al-CM) under acidic conditions. Complete dissolution of steel coupon after immersion in concentrated HCl for 24 hours is clearly shown in Figure 3A1. However, Figure 3B1 and B2 show the protection of steel coupons by biofilm of A. pullulans spi 10 up to 24 hours further exposure to concentrated HCl resulted in dissolution of steel coupon.
![]() | Figure 1: Phylogenetic relationship of two isolates (cau 19 and spi 10) of A. pullulans with other members of A. pullulans and related genus Kabatiella using the neighbor-joining method. Sequences of other strains were obtained from GenBank. Dothichiza pithyophila was used as an out group. Numbers at nodes indicate percentages of bootstrap sampling from 1,000 replication. Accession numbers are shown in brackets. [Click here to view] |
![]() | Figure 2: Time course of pullulan production and cell growth. The culture was grown in medium 2.0% dextrose, 0.06% ammonium sulfate ((NH4)2SO4), 0.5% dipotassium hydrogen orthophosphate (K2HPO4), 0.1% sodium chloride (NaCl), and 0.04% yeast extract at 25°C pH 5 in shaking condition (120 rpm). The growth (biomass dry weight) and pullulan in the culture supernatant were estimated at indicated days. ( ) = pullulan; ( ) = biomass dry weight. Each data point represents the mean of three replications and bars represent standard deviation from the mean. [Click here to view] |
![]() | Table 3: Summary of t-test conducted after immersing steel coupons (with and without protective agents) in HCl for 24 hours. [Click here to view] |
Figure 3C1 and C2 confirm the mitigation of corrosion of steel coupon by pullulan coating, it is very clear to observe that even after immersion of steel coupons in concentrated HCl for 48 hours metal loss is negligible. This result is supported by the metal loss shown in Table 2. In order to inhibit the corrosion of metal, the inhibitor should get adsorbed on the surface of metal, this is usually carried out by displacement of water from the surface of metal [32,33]
FTIR technique is based on the fact that the vibration of group of bonds take place at specific frequency. This technique is used to find out the functional groups involved in the formation of particular covalent bond.
FTIR spectra of pullulan are depicted in Figure 4B, stretching at 3,286.70 cm−1 represents the stretching vibration of –OH group and NH group, these groups are characteristic of alcohol, phenol and amines, respectively. The adsorption band at 2,933.73 and 3,271 cm−1 can be allocated to the –CH stretching of aldehyde group. Peaks at 1,408.04 and 1,253.73 cm−1 corresponds to the presence of –C–OH and –OH in alcohol group. Stretching at 1,361, 1,408, and 1,631 cm−1 represent the vibration of phenol, The absorption at 921.06 cm−1 is mainly because of stretching vibration of substituted benzene ring. The FTIR spectra of pullulan show the presence of –OH groups , which may provide binding site for divalent cations.
![]() | Figure 3: (A1) Steel coupon after immersion in concentrated HCl for 24 hours; (A2) Steel coupon after immersion in concentrated HCl for 48 hours; (B1) Steel coupon coated with biofilm of A. pullulans spi 10 immersed in concentrated HCl for 24 hours; (B2) Steel coupon coated with biofilm of A. pullulans spi 10 immersed in concentrated HCl for 48 hours; (C1) steel coupon layered with pullulan immersed in concentrated HCl for 24 hours; and (C2) steel coupon layered with pullulan immersed in concentrated HCl for 48 hours. [Click here to view] |
![]() | Figure 4: (A) FTIR spectrum of pullulan in the range of 500–4,000 cm-1. (B) FTIR spectrum of surface of steel coupon coated with pullulan and immersed in concentrated HCl. (C): FTIR spectra of surface of steel coupon. [Click here to view] |
Figure 4A shows the FTIR of steel coupons coated with pullulan and then exposed to HCl. The stretching at 3,485.37 cm−1 represents the stretching vibration of –OH group and it is characteristics of alcohol and phenol. Peaks at 1,805.37 and 1,691.57cm−1 corresponds to the presence of –C=O stretching of carbonyls. The peak at 2,962.66 cm−1 could be because of stretching –C=O of carboxylic acid. The adsorption band at 891.11 cm−1 can be assigned to the –OH stretching of carboxylic acid. FTIR spectra of pullulan show the presence of carboxyl group, which can be the binding site for divalent cations [34]. Presence of hydroxyl, carboxyl, and phosphoric acid functional groups on pullulan attribute to high affinity toward some metal ions. The different proportions of functional groups in various EPS had different influences on the corrosion [19].
![]() | Table 4: Summary of potential of biofilm of Aureobasidium pullulan spi 10 and pullulan to control the corrosion of steel coupon. [Click here to view] |
The difference between Figure 4A and B reveals that stretching at 1,630 cm−1 characteristics of pullulan is shifted to 1,690 cm−1 when pullulan is coated on metal; this is due to interaction between aromatic ring of pullulan with metal. Similarly, Figure 4B shows that intensity of stretching at 3,286 cm−1 is reduced when pullulan interacted with metal.
Figure 4C shows the FTIR stretching band related to steel coupons. The absorption band at 3,045.60 and 2,962 cm−1 usually represents the stretching vibration of =C–H of alkene group. Absorption at 2,314.58 and 1,973 cm−1 can be attributed to the –C=C bonds. The absorption band at 1,691.57 cm−1 reveals –C–C stretching.
3.5. Surface Study of Steel Coupons
The surface of steel coupons was studied by SEM.
Figure 5A and B shows that the steel coupons under acidic conditions get severely corroded because of strong acid attack. Under higher magnification, surface of steel coupons seems to be rough because of loss of an electron by Fe which leads to formation of Fe+2 which further losses electron and produces Fe+3 species [35]. These Ferric ions (Fe+3) have detrimental effect on mild steel, consequently results in formation of pits and intergranular. The observed lamellae are attributed to formation of FeCl2 crystals as a product of corrosion.
![]() | Figure 5: SEM image of metal coupons (A and B) immersed in concentrated HCl, (C and D) immersed in concentrated HCl along with biofilm of A. pullulans spi 10, and (E) immersed in concentrated HCl along with coating of pullulan. [Click here to view] |
Figure 5C and D shows the formation of biofilm by A. pullulans spi 10; it is because of adequate adhesive potential of selected strain. Similar type of biofilm was also formed by L. delbrueckii K27 showing the potential of EPS to control the corrosion of mild steel [17].
Figure 5E shows the layer of pullulan on the surface of metal, thus it forms the safeguarding fence between the metal surface and environment. This image confirms the surface assimilation of pullulan on the steel coupons. The adherence of pullulan to metal surfaces is facilitated by the interlinkage of metal ions and the functional groups of the pullulan. These interlinkages attribute to change the redox potential of Fe (II)/Fe (III). Thus the protective barrier of pullulan reduces the number of electron acceptors by binding to Fe(II) and Fe(III) [36]. Certain polysaccharides show potential to mitigate the corrosion because of very high stability constant for Fe3+ ions [6]. Charitha [31] has reported that after treating Al-CM with pullulan, it leads to formation of very smooth surface and this was confirmed by SEM analysis. Pullulan gets protonated and gets attracted towards the negative surface and prevents the further oxidation of metal. The process of surface assimilation is controlled by the charge on the facet of the metal in an aggressive environment. When the metal ions show positive charge, it favors the surface assimilation of negatively charged chloride ions, eventually protonated pullulan would not get assimilated on the metal surface. On the contrary, when metal ions have negative charge, because of electrostatic attraction protonated pullulan forms the physical barrier on the metal surface. This layer of pullulan reduces the direct exposure of metal surface with aggressive environment and ultimately it contributes to reduce the metal loss because of corrosion [37,38].
4. CONCLUSION
The result of the present study recommends that A. pullulans spi 10 isolated from the leaves of spinach vegetables is found to be a good source for pullulan production. The data showed that the biofilm of A. pullulans spi 10 can serve as a corrosion inhibitors. In addition to pullulan produced by the same strain, it is found to be a reliable source to mitigate the corrosion of mild steel.
5. AUTHORS’ CONTRIBUTIONS
All authors have contributed significantly in carrying out the experiments, collection of data, analysis and interpretation of data, in drafting the article, or revising it critically. All authors gave consent for submission of manuscript to this journal.
6. ACKNOWLEDGMENTS
The authors are thankful to the Principal of Tuljaram Chaturchand College of Arts, Commerce and Science for providing necessary research facilities to conduct the study. The authors would like to express their gratitude toward the Coordinator of CFC, Tuljaram Chaturchand College of Arts, Commerce and Science for FTIR analysis.
7. CONFLICT OF INTEREST
The authors declare no conflict of interest.
8. FUNDING
This study was supported by a grant received from Tuljaram Chaturchand College under the title of Student Research Project.
REFERENCES
1. Mattson E. Basic corrosion technology for scientists and engineers, ch.3. Ellis Horwood Publishers, West Sussex, UK, 1989; doi:http://doi.org/10.1007/978-1-84800-074-2-1.
2. Tiu BD, Advincula RC. Polymeric corrosion inhibitors for the oil and gas industry: design principles and mechanism. React Funct Polym 2015;95:25–45; doi: http://dx.doi.org/10.1016/j CrossRef
3. Verma C, Ebenso EE, Quraishi MA, Hussain CM. Recent development in sustainable corrosion inhibitors: design, performance and industrial scale applications. Mater Adv 2021;2:3806–50; doi: http://doi.org/10.1108/00035590010310003 CrossRef
4. Aljeaban NA, Goni LKMO, Alharbi BG, Mazumder MAJ, Ali SA,Chen T, et al. Polymers decorated with functional motifs for mitigation of steel corrosion: an overview. Hindawi Int J Polym Sci 2020:1–23. CrossRef
5. Manu SK, Manivannan R. A review on the role of eco-friendly inhibitors for mitigation of microbial influenced corrosion of steel and its impacts. IOP Conf Ser Mater Sci Eng 2021;1057:1–10; doi:10.1088/1757-899X/1057/1/012002 CrossRef
6. Ignatova-Ivanova TV, Ivanov R. Study of biofilm formed by lactic acid bacteria on the surface of mild steel. J Life Sci 2014;8:799–804.
7. Ruiz L, Valenzuela S, Castro M, Gonzalez A, Frezza M, Soule`re L, Rohwerder T, et al. AHL communication is a widespread phenomenon in biomining bacteria and seems to be involved in mineral-adhesion efficiency. Hydrometallurgy 2008;94:133. CrossRef
8. Wallenfels K, Keilich G, Bechtler G, Freundenberger D. Study on pullulan IV. Clarification of structural problems with physical, chemical and enzymatic methods. Biochem Z 1986:79–86.
9. Leathers TD. Substrate regulation and specificity of amylases from Aureobasidium strain NRRL Y-12, 974. FEMS Microbiol Lett 1993;110:217–22. CrossRef
10. Shingel KI. Current knowledge on biosynthesis, biological activity, and chemical modification of the exopolysaccharide, pullulan. Carbohydr Res 2004;339(3):447–60; doi: 10.1016/j.carres.2003.10.034. PMID: 15013381. CrossRef
11. Catley BJ, Ramsay A, Servis C. Observations on the structure of the fungal extracellular polysaccharide, pullulan. Carbohydr Res 1986:79–86. CrossRef
12. Pollock TL, Thone RW. Armentrout. Isolation of new Aureobasidium strains that produce high molecular weight pullulans with reduced pigmentation. Appl Environ Microbiol 1992;58:877–83. CrossRef
13. Thirumavalavan TR, Manikkandan, Dhanasekar R. Batch fermentation kinetics of pullulan from Aureobasidium pullulans using low cost substrate. Biotechnology 2008;7(2):317–22. CrossRef
14. Lowry OH, Rosebrough NJ, Farr AL, Randall RJ. Protein measurement with the folin phenol reagent. J Biol Chem 1951;193(1):265–75. CrossRef
15. Dubois M, Gilles KA, Hamilton JK, Rebersb PA, Smith F. Colorimetric method for determination of sugars and related substances.1956;28(3). CrossRef
16. Shang N, Xu R, Li P. Structure characterization of an exopolysaccharide produced by Bifidobacterium animalis RH. Carbohydr Polym 2013;84. CrossRef
17. Ignatova-Ivanova TS, Ivanov R. Exopolysaccharides from lactic acid bacteria as corrosion inhibitors. Acta Sci Nat 2016;(3):51–9; doi: 10.1515/ash-2016-0008 CrossRef
18. Ibryamova S, Ivanov R, Ignatova-Ivanova TS. Study of anticorrosion effect of exopolysaccharide produced by Lactobacillus fermentum Ts cultivated on different carbohydrates. Res J Pharm Biol Chem Sci 2018;9(6):366–74.
19. Jin J, Wu G, Zhang Z, Guan Y. Effect of extracellular polymeric substances on corrosion of cost iron in the reclaimed wastewater. Bioresour Technol 2014;01:117. Available via www.elsevier.com/locate/biortech doi:10.1016/j.biortech.2014.01.117 CrossRef
20. Takahashi S, Itoh M, Kaneko Y. Treatment of phenolic waste by Aureobasidium pullulans adhered to the fibrous supports. Eur J Appl Microbiol Biotechnol 1981;13(3):175–8; doi:10.1007/BF00703049 CrossRef
21. Singh RR, Gaur GM, Gaur MK. Aureobasidium pullulans an economically important polymorphic yeast with special reference to pullulan. Afr J Biotechnol 2010;9(47):7989–97 CrossRef
22. Roukas T. Pullulan production from brewery wastes by Aureobasidium pullulans. World J Ind Microbiol Biotechnol 1999;15:447–50. CrossRef
23. Catley BJ. Utilization of carbon sources by Pullularia pullulans for the elaboration of extracellular polysaccharides. Appl Microbiol 1971;22(4):641–9. CrossRef
24. Wu S, Jin Z, Tong Q, Chen H. Sweet potato: a novel substrate for pullulan production by Aureobasidium pullulans. Carbohydr Polym 2009;76:645–9. CrossRef
25. Youssef F, Biliaderis CG, Roukas T. Enhancement of pullulan productions by Aerobasidium pullulans in batch culture using olive oil and sucrose as carbon sources. Appl Microbiol Biotechnol 1998;74:13–30. CrossRef
26. Bulmer MA, Catley BJ, Kelly PJ. The effect of ammonium ions and pH on the elaboration of the fungal extracellular polysaccharide, pullulan, by Aureobasidium pullulans. Appl Microbiol Biotechnol 1987;25(4):362–5. CrossRef
27. Cheng KC, Demirci A, Catchmark JM, Puri VM. Effects of initial ammonium ion concentration on pullulan production by Aureobasidium pullulans and its modeling. J Food Eng 2011;103:115–22. CrossRef
28. Gibbs PA, Seviour RJ. Does the agitation rate and/or oxygen saturation influence exopolysaccharide production by Aureobasidium pullulans in batch. Appl Biochem Biotechnol 1996;46(5–6):503–10. CrossRef
29. Evelin D, Stefan M, Ursula T, Jost W. Chemical and physical methods for characterisation of biofilms. Microchim Acta 2007;158(1):1–27; doi: 10.1007/s00604-006-0688-5 CrossRef
30. Karunakaran E, Biggs CA. Mechanisms of Bacillus cereus biofilm formation: an investigation of the physiological characteristics of cell surfaces and extracellular proteins. Appl Microbiol Biotechnol 2011;89(4):1161–75; 31.doi: 10.1007/s00253-010-2919-2. CrossRef
31. Charitha BP, Padmalatha R. Environmentally benign green inhibitor to attenuate acid corrosion of 6061aluminum-15%(v) SiC(P) composite. J Ind Eng Chem 2018; doi:10.1016/j.jiec.2017.09.049
32. Bereket G, Pinarbsi A. Electrochemical thermodynamic and kinetic studies of the behaviour of aluminium in HCl containing various benzotriazole derivatives. Corros Eng Sci Technol 2004;39:308–12. CrossRef
33. Bataineh TT, Al-Qudah MA, Nawafleh EM, Al-Rawashdeh NAF. Sinapis alba extract as green corrosion inhibitor for aluminum in alkaline media. Int J Electrochem Sci 2014;(9):3543–57.
34. Bramhachari PV, Kavi Kishor PB, Ramadevi R, Kumar R, Rama Rao B, Dubey SK. Isolation and characterization of BioMed Research International 11 mocous exopolysaccharide (EPS) produced by Vibrio furnissii strain VB0S3. J Microbiol Biotechnol 2007;17(1):44–51.
35. Majumdar I, D’souza F, Bhosle NB. Microbial exopolysaccharides: effect on corrosion and partial chemical characterization. J Indian Inst Sci 1999;79:539–50.
36. Finkenstadt VL, Côté GL, Willett JL. Willett Corrosion protection of low-carbon steel using exopolysaccharide coatings from Leuconostocmesenteroides. Biotechnol Lett 2011;33:1093–100; doi: 10.1007/s10529-011-0539-2. CrossRef
37. Pinto GM, Nayak J, Shetty AN. Adsorption and inhibitor action of 4-(N,Ndimethylamino) benzaldehyde thiosemicarbazone on 6061 Al/SiC composite and its base alloy in sulfuric acid medium. Synth React Inorg Met Org Chem 2014;41:127–40. CrossRef
38. Tschapek M, Wasowski C, Torres Sanchez RM. The PZC and IEP of γ-A12O3 and TiO2. J Electroanal Chem 1976;74:167–76. CrossRef